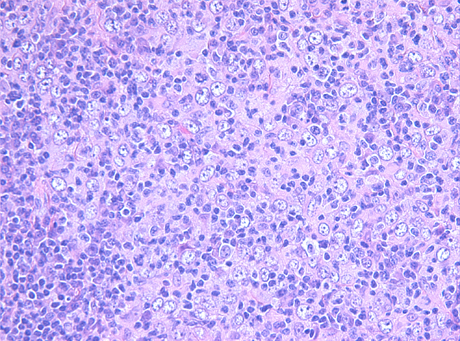

3.a.iii.3 Lymphoepithelioma-Like Variant



Click to enlarge image
Lymphoepithelioma-like carcinoma of the cervix is an uncommon variant of poorly differentiated non-keratinizing squamous cell carcinoma. Its morphology is similar to that of the nasopharyngeal lymphoepithelioma-like carcinoma. Malignant cells show abundant eosinophilic cytoplasm with large nuclei and prominent nucleoli. The cellular borders are indistinct, which confers a syncytial appearance. The carcinoma is accompanied by an intense inflammatory reaction. The main differential diagnosis is lymphoma: identification of cohesive cellular clusters and positive immunohistochemical staining for p63 or cytokeratin 5/6 usually easily confirm the diagnosis. Epstein-Barr virus DNA has been identified in some cases in the Asian population, but only rarely in the western population. Therefore, the role of EBV in the pathogenesis of lymphoepithelioma-like carcinoma is uncertain and there might be geographical variations. The role of human papilloma virus infection also remains unclear.
Contact Information
Gynecologic Pathology
Room E-436,
2075 Bayview Avenue,
Toronto, Ontario
M4N 3M5
Admin. Assistant/Clerical Supervisor
Lesley Nicholson
lesley.nicholson@
sunnybrook.ca
Tel: 416-480-4009